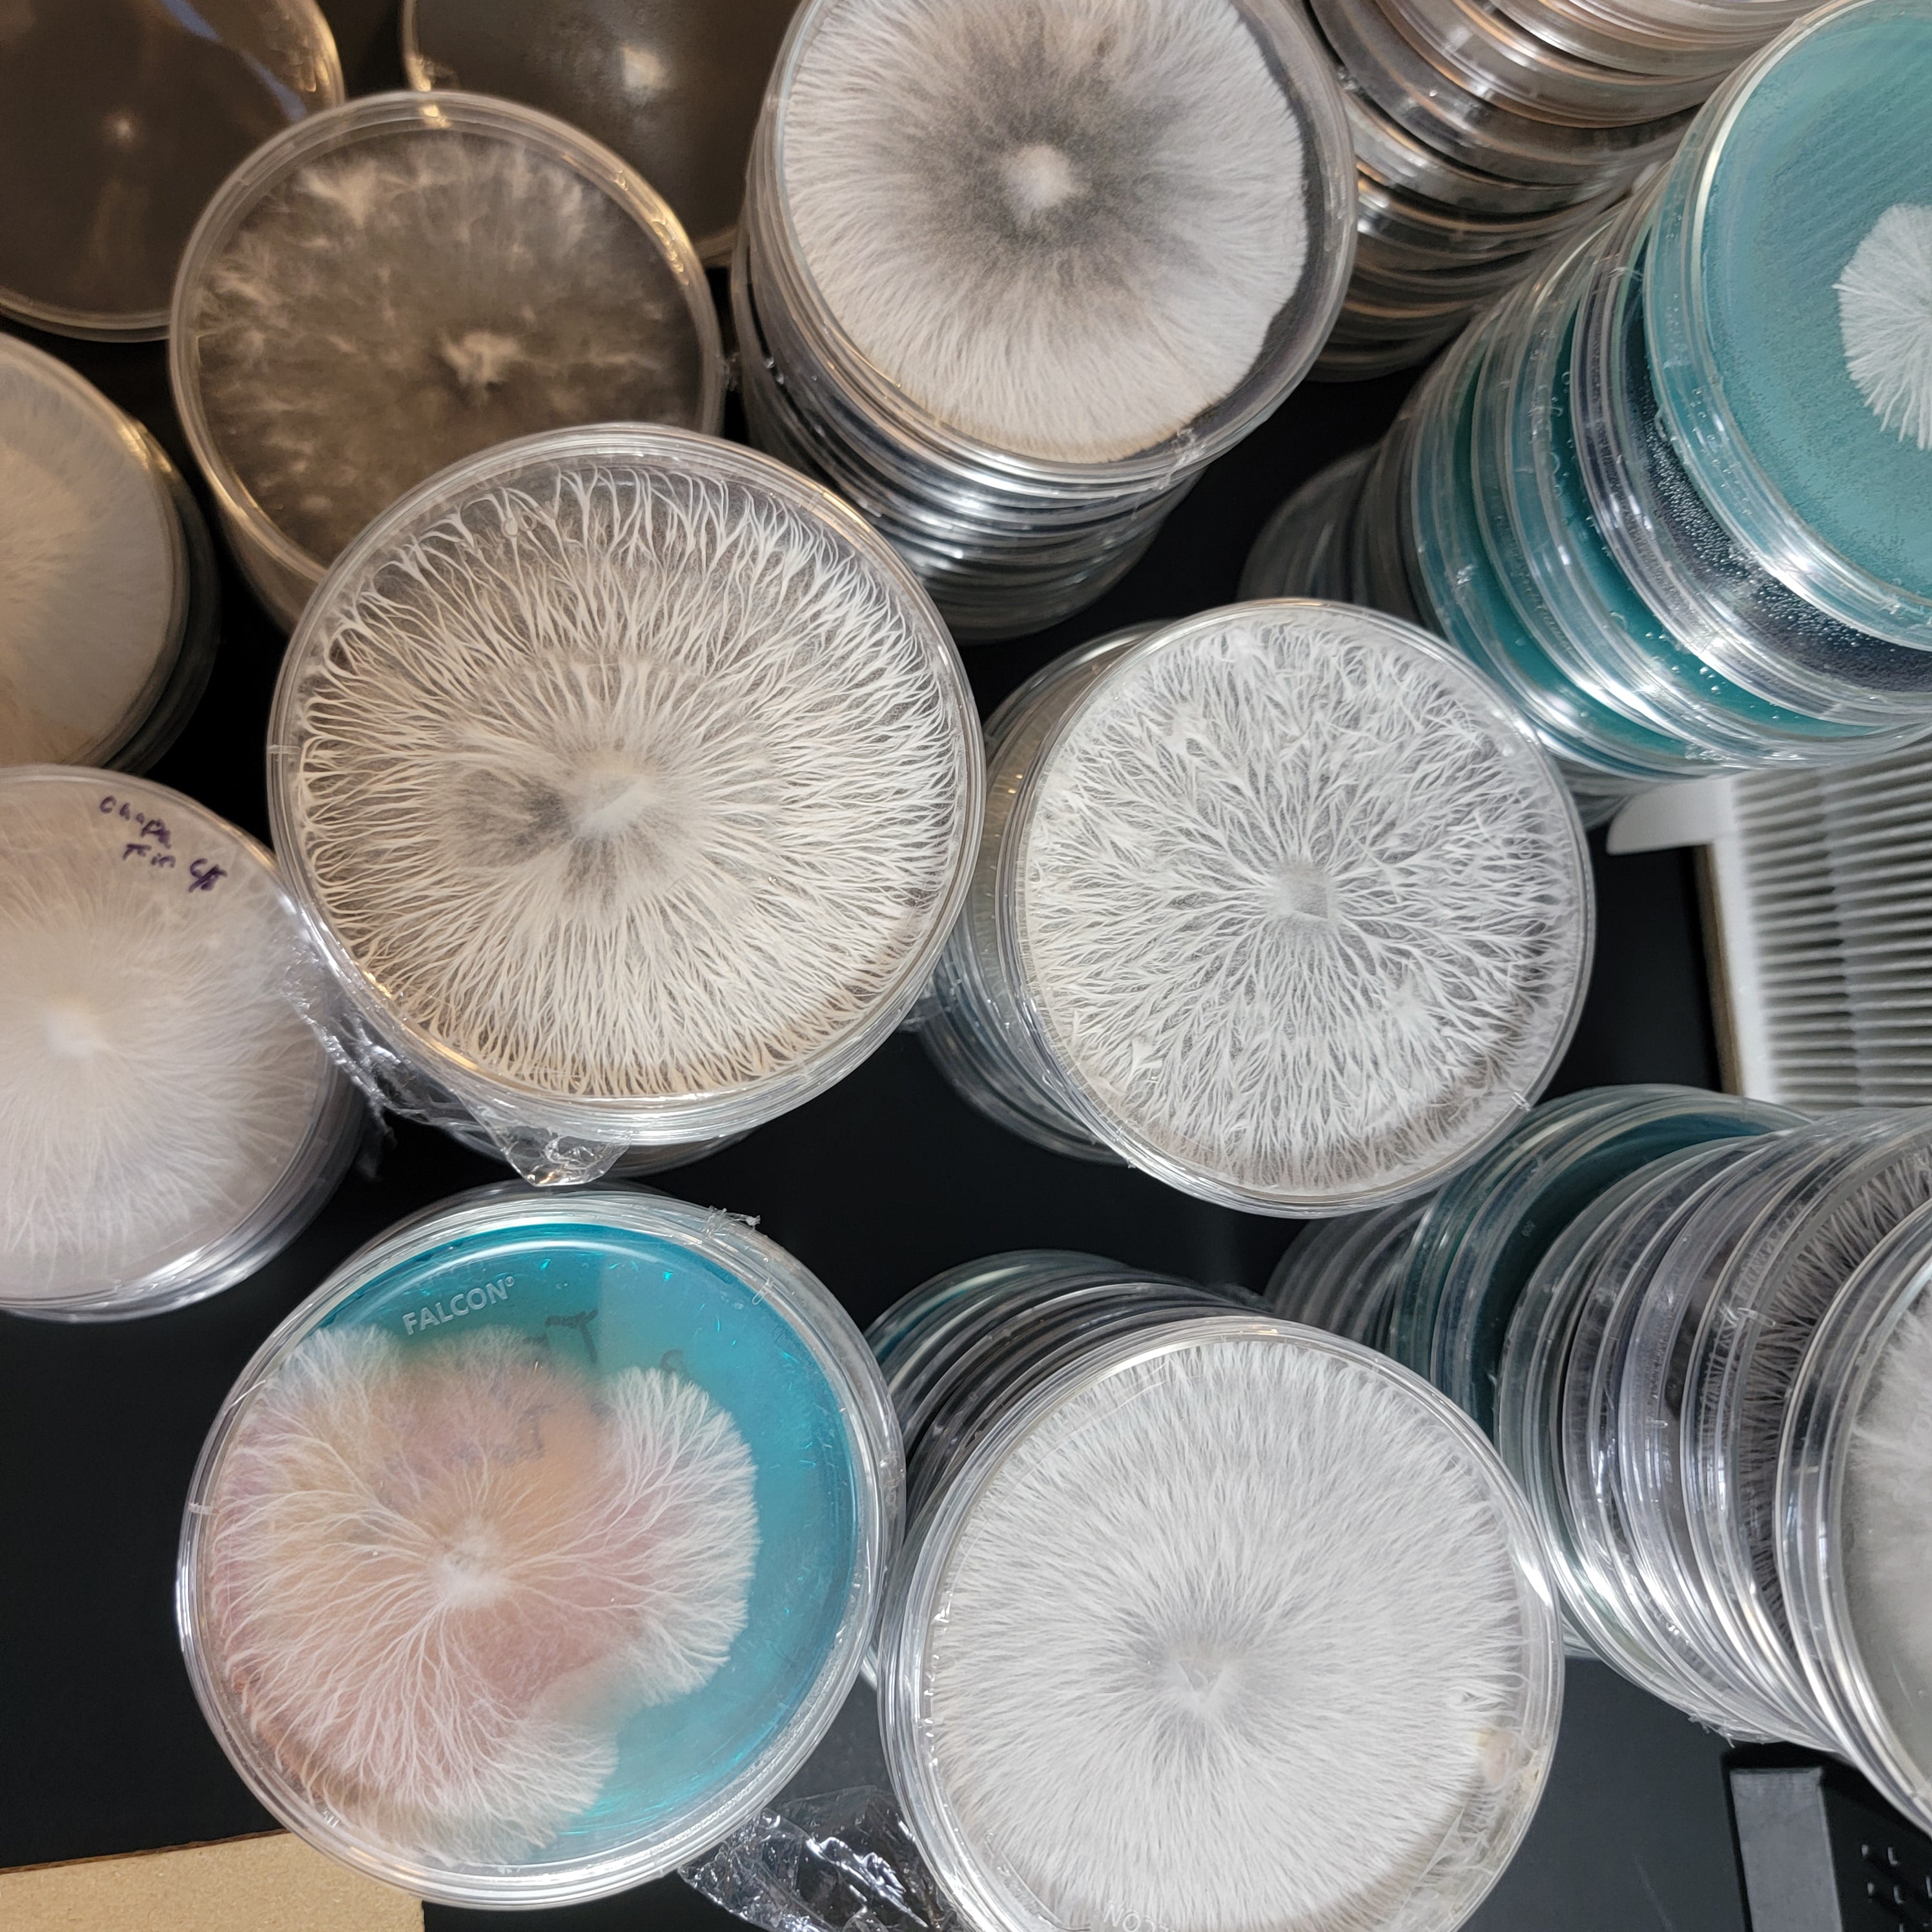

New product customizer is live! Click "Design Your Own" to add text or change the color scheme of any item you wish to order.
Products
-
Design Your Own Equipment
Design your own lab from the ground up! Build your equipment how...
Products I use
View all-
Hole saws for monotubs.
I use the 2 1/4 inch hole saw for my upper holes, and 1 inch holes for my lower holes. I found these hole saws on Amazon are good quality...
Hole saws for monotubs.
I use the 2 1/4 inch hole saw for my upper holes, and 1 inch holes for my lower holes. I found these hole saws on Amazon are good quality...
-
Scalpel with 20 sterile blades
I love this kit! This is the scalpel and blades I have been using for months now and I love this shape blade the most. You can also order just...
Scalpel with 20 sterile blades
I love this kit! This is the scalpel and blades I have been using for months now and I love this shape blade the most. You can also order just...
-
Latex gloves
I love these gloves the most! They're very strong and easy to put on, and a great price too! https://amzn.to/3S0OxkN
Latex gloves
I love these gloves the most! They're very strong and easy to put on, and a great price too! https://amzn.to/3S0OxkN
Upcoming Events
-
Blog post
Give your customers a summary of your blog post
Blog post
Give your customers a summary of your blog post
-
Blog post
Give your customers a summary of your blog post
Blog post
Give your customers a summary of your blog post
-
Blog post
Give your customers a summary of your blog post
Blog post
Give your customers a summary of your blog post
If you would like me to make you a custom product that is not listed on my site, please reach out to me. I am willing to make you whatever you need that I can make! Such as grain bags, custom size HEPA filters, fruiting chambers and tubs, or other equipment. I can also source gourmet cultures for you. Use the button below or the contact form to get a hold of me via email and we can work something out!
Subscribe to our emails
Be the first to know about new collections and exclusive offers.

16x12 Flow Hood
Laminar flow hoods provide a sterile environment that is ideal for mycology.

High power induction heater
12V 1A high power induction heater, this puppy will heat a scalpel to glowing hot in 5 seconds or less with the press of a pedal.

Gourmet culture cups
Fungi you can eat! These are gourmet / edible cultures on agar!
